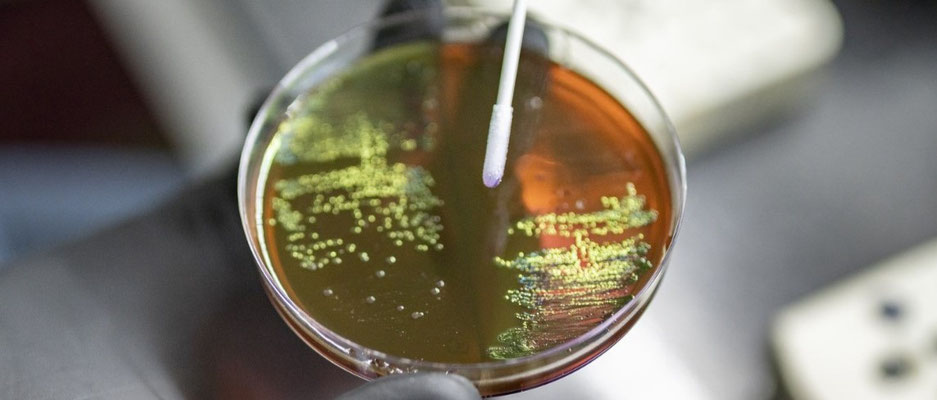

MISSION
OUR #1 MISSION
supporting professional Australian poultry companies in producing
HEALTHY, SAFE and NUTRITIOUS food
OUR #2 MISSION
to apply our innovative natural supplements (GMP+ FSA assured)
to contribute to
the Sustainable Development Goals
of the United Nations:
● SUPPORT AUSTRALIAN POULTRY COMPANIES
● PROMOTE SUSTAINABLE AGRICULTURE
● ACHIEVE FOOD SECURITY
● IMPROVE NUTRITION
● END HUNGER
OUR #3 MISSION :
to make a substantial contribution to
the PREVENTION and REDUCTION of Antimicrobial Resistance (AMR)
World Health Organization (WHO):
'Antimicrobial resistance (AMR) is one of the top global public health and development threats'
WHO: 'Antimicrobial resistance (AMR) threatens the effective prevention and treatment of
an ever-increasing range of infections caused by bacteria, parasites, viruses and fungi.
The misuse and overuse of antimicrobials in humans, animals and plants
are the main drivers in the development of drug-resistant pathogens.
It is estimated that bacterial AMR was directly responsible for
1.27 million global deaths in 2019 and contributed to 4.95 million deaths.'
Click on one of the pictures above and read the article in The Lancet:
'Global burden of bacterial antimicrobial resistance : a systematic analysis'
author: Antimicrobial Resistance Collaborators